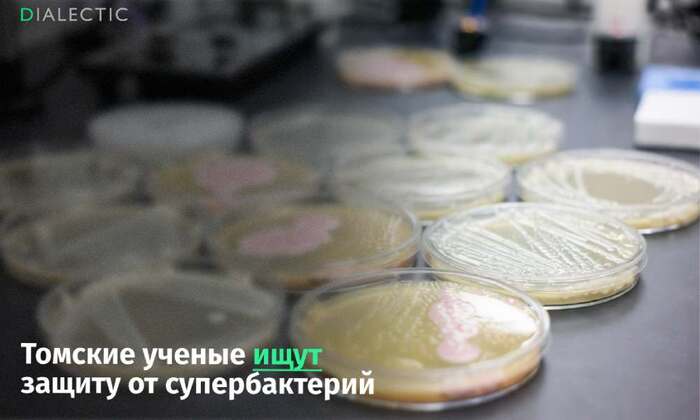

Преимущественно я пишу про технологии, биотехнологии, что-то, что касается исследований тела. Но каждый сторонник ЗОЖа знает, что в основе всегда лежат: подвижность, сон и питание. Поэтому в материале разберем, какие именно продукты вошли в топ суперфудов 2024 года, в чем именно заключается их ценность, а от каких продуктов наоборот, стоит держаться подальше.
Сыр для улучшения психического здоровья в пожилом возрасте
В исследовании с выборкой 2,3 миллиона человек, исследователи из Медицинской школы Шанхайского университета Цзяотун обнаружили связь между потреблением сыра и улучшением психического здоровья и ощущения благополучия среди стареющего населения, независимо от социально-экономических факторов.
Исследование рассматривало психическое благополучие на основе генетически независимого фенотипа старения (aging-GIP) и пяти общих черт фенотипа «здорового старения» — устойчивость, самооценка здоровья, продолжительность функциональной жизни, продолжительность жизни родителей и общее число прожитых лет.
Хотя это было больше перебором данных, чем исследованием, но его результаты указали на корреляцию между потреблением сыра и продолжительностью жизни. Причем значимость сыра важна настолько же, как и социализация. Что включает сыр в топ суперфудов как минимум 2024 года.
Орехи помогают защитить мозг от слабоумия
Исследователи из Университета Монаша в Мельбурне изучили субъективные репорты 9916 человек старше 70 лет, которые прошли опрос по частоте употребления продуктов из 49 пунктов. После отсеивания других факторов ученые обнаружили, что люди, сообщавшие о потреблении горсти орехов как части своего рациона один или два раза в день, имели больше шансов сохранить здоровые когнитивные функции и физическое здоровье. По сравнению с людьми, которые не потребляли орехов.
Лисьи орехи — новый суперфуд?
Западный мир проникся интересом к добавке, которая давно используется в традиционной медицине в Юго-Восточной Азии и Индии. Речь идет о лисьих орехах. К счастью, эти орехи не добывают из животных. Это мясистые круглые ядра внутри семян цветка Eurale ferox, водного растения, принадлежащего к семейству водяных лилий.
Их антивозрастные свойства представляли особый интерес для исследователей. Работы 2012, 2018, 2020 и 2023 годов были сосредоточены вокруг содержащихся в этих орехах антиоксидантов.
Отмечалось наличие ключевых соединений, которые важны для здоровья клеток и противодействия воспалению. Богатые белком и крахмалом орехи, которые можно «лопнуть», как попкорн, традиционно также использовались для борьбы с ожирением и высоким уровнем холестерина.
Супер-протеин из воздуха
В 2024 году в Финляндии открылась первая в мире фабрика по производству белка из атмосферы в коммерческих масштабах. Белок, Solein (Sol ar-prot ein) от Solar Foods, производится одноклеточным почвенным микроорганизмом, который окисляет водород для получения энергии.
Конечным результатом стало порошкообразное вещество, известное как Solein, которое содержит 65-70% белка, 5-8% жира, 10-15% пищевых волокон и 3-5% минеральных питательных веществ. А для его производства требуется в 100 раз меньше воды и в 20 раз меньше земли, чем для производства растительного белка, при этом цикл производства производит 1/5 объема от допустимых выбросов углерода.
Черный шоколад и снижение рисков диабета
Темный шоколад — спорная тема в мире исследований, его польза для здоровья горячо обсуждается. В этом году исследователи Гарвардской школы общественного здравоохранения имени Чана обнаружили, что употребление 30 грамм горького лакомства 5 раз в неделю было связано с 21%-ным снижением риска развития диабета 2 типа — без увеличения веса. Хотя анализ данных о состоянии здоровья, предоставленных 200 000 взрослых американцев, требует дальнейшего изучения, исследователи полагают, что продукты из какао с высоким содержанием флаванола улучшают резистентность к инсулину, чего не наблюдается в других формах шоколада. Флаванолы, полифенольные антиоксиданты, связаны с улучшением здоровья сердца и снижением риска диабета 2 типа. Теперь исследователи надеются раскрыть механизм, который мог бы объяснить связь, обнаруженную ими в их данных.
Мёд + йогурт = суперфуд
Исследователи из Университета Иллинойса в Урбане-Шампейне обнаружили, что добавление столовой ложки меда в йогурт помогает полезным пробиотикам выживать в кишечнике. Хотя есть множество доказательств того, что культуры бактерий, обнаруженные в йогурте, увеличивают популяцию полезных бактерий в кишечнике, что может помочь уменьшить воспаление и улучшить пищеварение, проблема заключается в том, чтобы доставить пробиотики вглубь пищеварительной системы без потерь.
Ученые обнаружили, что мед, особенно клеверный мед, защищает полезные бактерии, когда они проходят через верхний отдел желудочно-кишечного тракта к микробиому кишечника. Там эти пробиотики максимально полезны для организма.
Клубника может помочь организму подавить аллергию
Исследование Токийского университета науки показало, что флавоноид кемпферол может ослаблять аллергическую реакцию организма, включая случаи пищевой аллергии, посредством воздействия на иммунную систему.
Кемпферол в изобилии содержится в чае, фасоли, брокколи, яблоках и клубнике. Ученые обнаружили, что этот специфический флавоноид действует как микробиологический антагонист в кишечнике, что в конечном итоге увеличивает количество регуляторных Т-клеток (T-regs), которые подавляют аллергическую реакцию организма.
Исследователи продолжат изучать противовоспалительное и иммуносупрессивное действие кемпферола как многообещающий способ лечения аллергии.
Фрукты поддерживают здоровье стареющего мозга
Исследователи из Национального университета Сингапура изучили данные 13 738 человек за почти два десятилетия и обнаружили, что у людей, которые съедали около трех или более порций фруктов в день в среднем возрасте, примерно на 21% был ниже риск развития «симптомов депрессии» в последующие годы. Таким может и не понадобиться КПТ терапия.
К этим симптомам относятся замедление когнитивных функций, бессонница, плохая концентрация и повышенная утомляемость. Ведущий исследователь Вун-Пуай Кох, профессор медицины NUS, добавил: «Наше исследование подчеркивает важность потребления фруктов в качестве профилактической меры против депрессии, связанной со старением».
Топ суперфудов и продукты с рисками. Куркума и зеленый чай приводят людей в больницу
Исследователи из Мичиганского университета в Энн-Арбор обнаружили, что около 15 миллионов американцев могут подвергать риску печень, переусердствуя с популярными добавками. В статье перечислены: куркума, зеленый чай, ашваганда, G. cambogia, черный кохош и красный дрожжевой рис.
Почти 5% населения регулярно принимают по крайней мере один из перечисленных ингредиентов для лечения всего: от боли в суставах до стресса. Рост госпитализаций из-за гепатотоксичности — повреждения печени, вызванного неправильным использованием добавок, заставил исследователей призвать людей к осторожности.
Впрочем, перечисленные случаи госпитализации связаны с тем, что люди закидывали в себя перечисленные продукты просто горстями.
Скрытая опасность арбуза
Три случая, опубликованные в журнале Annals of Internal Medicine, пролили свет на количество калия, содержащегося в арбузе, и для людей с хроническим заболеванием почек переедание может быть опасным для жизни .
Большинство из нас знает, что этот фрукт содержит много воды — около 92%. Но упускается из виду факт, что в арбузе много калия. А в случаях, представленных в журнале, у трех пациентов с какой-либо формой хронического заболевания почек развилась гиперкалиемия, и им потребовалась госпитализация в отделение интенсивной терапии после употребления большого количества арбуза в течение периода от трех недель до двух месяцев.
Гиперкалиемия, состояние, вызванное высоким уровнем калия, имеет ряд симптомов, когда оно прогрессирует в степени тяжести, с ранними признаками боли в груди и учащенного сердцебиения, которые становятся более серьезными и даже опасными для жизни.
Какой вывод про топ суперфудов?
Любая еда опасна, если её закидывать в себя постоянно. 30 г шоколада в день, 2 горсти орехов, пара кружек кофе и чая, йогурт с 1-2 чайными ложками меда. Все это не так сложно, но… требует регулярности. И понимания, как это работает.
Сегодня, 31 декабря, желаю каждому читателю, чтобы в новом году ваши планы реализовывались, цели достигались, а приятных моментов было больше. А как чуть больше притопить педаль продуктивности – рассказывают материалы сообщества. Подписывайтесь, чтобы не пропустить новые статьи!